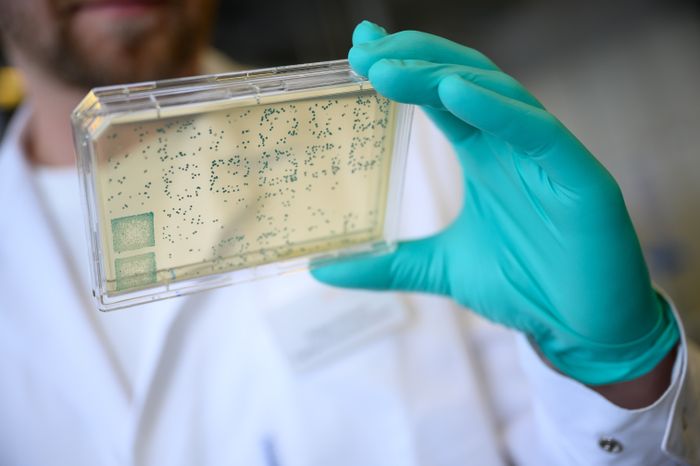
Get Zurueckzubekommen Desktop Wallpaper Zurueckzubekommen

Zurueckzubekommen
Get Zurueckzubekommen Desktop Wallpaper Free
Download Zurueckzubekommen For Free - Top Rated Ultra HD Desktop Background Wallpapers for 4K & 8K UHD TV : Widescreen, Ultra Wide & Multi Display Desktops & Tablet.. Today i will share Zurueckzubekommen wallpaper. At The Best Wallpaper Place you will find a large assortment of designer and glitter wallpaper. Choose your designer wallpaper online today.

Get Zurueckzubekommen HD

Get Zurueckzubekommen For Android

Download Zurueckzubekommen Desktop Wallpaper Free

Get Zurueckzubekommen For iPhone

Get Zurueckzubekommen Desktop Wallpaper
Get Zurueckzubekommen For iPhone

Download Zurueckzubekommen For Android Free

Get Zurueckzubekommen Desktop Wallpaper Free
Get Zurueckzubekommen Desktop Wallpaper

Get Zurueckzubekommen Desktop Wallpaper
Get Zurueckzubekommen For Android
Get Zurueckzubekommen For Free

Download Zurueckzubekommen Free HD

Get Zurueckzubekommen For Android Free
Download Zurueckzubekommen For iPhone Free